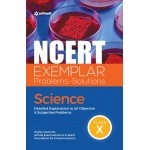
Arihant Publication India Limited NCERT Exemplar Problems-Solutions Science class 10th

Arihant Publication India Limited NCERT Exemplar Problems-Solutions Science class 10th
(0)
0 sold. Only 1 remain
د.إ35.00
Ex Tax: د.إ35.00
OverView
Arihant Publication India Limited NCERT Exemplar Problems-Solutions Science class 10th